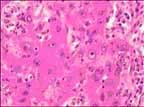
Non Small Cells

Get
a Free
Info Packet

FOR MORE INFORMATION
please call
1-800-400-1805
We will gladly answer your questions and send you a free packet with additional
information on:
- New treatment options
- New clinical trials
- Doctors
- Hazardous jobs and products
- Veteran's Resources
- Financial Assistance
Non Small Cell Lung Cancer
is more common than small cell lung cancer accounting for approximately 85% of all cases of lung cancer. Non Small Cell Lung Cancer generally grows and spreads more slowly than Small Cell Lung Cancer. There are three main types of non-small cell lung cancer. They are named for the type of cells in which the cancer develops: squamous cell carcinoma (also called epidermoid carcinoma), adenocarcinoma, and large cell carcinoma.
Adenocarcinoma: Usually beginning in the mucous glands, adenocarcinoma is the most frequently diagnosed type of lung tumor, accounting for forty percent of all cases. Women are more likely to develop adenocarcinoma than any other Non Small Cell Lung Cancer.
Squamous Cell Carcinoma:Squamous cell carcinoma causes 30 to 35 percent of all cases. Slow growing, squamous cell carcinoma usually begins in the bronchial tubes, and diseased nodules tend to be clumped together.
Large Cell Carcinoma: The least common form of Non Small Cell Lung Cancer, large cell carcinoma occurs in approximately five to fifteen percent of all cases. Tumors may develop in isolation, or in masses. The prognosis is worse than for squamous carcinomas, and tumors tend to be large at the time of diagnosis.
Undifferentiated: The variety of Non Small Cell Lung Cancer cannot be determined. As Non Small Cell Lung Cancer classifications are all treated in much the same way, an undifferentiated diagnosis does not usually affect treatment outcome.
Cigarettes, radon and asbestos exposure are the leading causes of Non Small Cell Lung Cancer. Surgical removal of the diseased tissue is the usual treatment option, although radiation therapy and chemotherapy may also be used, depending on tumor growth and spread.
Notice the abundance of pink cell contents (cytoplasm) around the round blue nuclei. This makes the cells "Large."
Notice the abundance of pink cell contents (cytoplasm) around the round blue nuclei. This makes the cells "Large."

Free Mesothelioma Information
- New Treatment Options
- Clinical Trials
- Best Doctors
- Veteran's Resources
- Financial Assistance
1-800-400-1805


